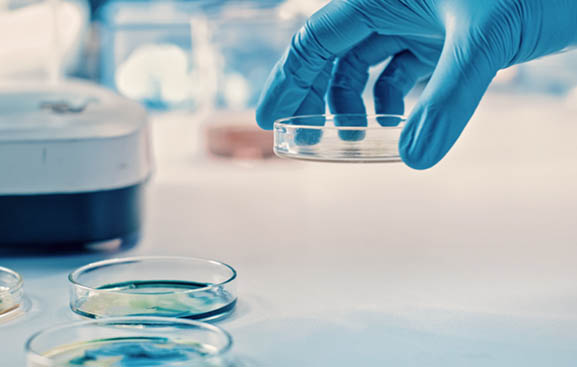

Passer d’une médecine curative à une médecine préventive et personnalisée
Apporter une solution innovante de
détection précoce et de suivi de l'infection.
40% des décès
des soins intensifs sont dûs au sepsis10% des patients
traités par une chimiothérapie développent une neutropénie90% des patients
souffrant de neutropénie pendant plus de 7 jours développeront de la fièvre18% de mortalité
supplémentaire sont observés à chaque heure de retard dans la prise en charge du choc septiqueDe l'importance de mesurer la température centrale et ses variations
La fièvre étant l’un des premiers signes de l’infection, la température fait partie des constantes mesurées régulièrement à l’aide de thermomètres tympaniques, axillaires, rectaux ou infrarouges sans contact.
Pourtant la littérature scientifique montre sans ambiguïté que la mesure périphérique (tympanique, axillaire, frontale…) reste imprécise, non standardisée et parfois trompeuse. Les écarts peuvent être conséquents selon les méthodes utilisées et aucun consensus clinique n’existe sur leur interprétation. Par ailleurs, la valeur dite « normale » de 37 °C ne tient pas compte de la température de base individuelle.
C’est sur la base de ce constat que F2D Medical a engagé sa démarche de recherche et développement.
L’objectif : rendre accessible en continu et sans contrainte la mesure la plus fiable qui soit : celle de la température centrale.
Gold standard clinique visé : la sonde urétrale reconnue pour sa précision dans les services de soins critiques.
À l’issue de 5 ans de R&D, essais cliniques, boards scientifiques, calibrages d’algorithmes… Thermodiag a atteint ce niveau de fiabilité avec une erreur moyenne absolue de 0,35°C.
Non seulement la mesure est fiable mais le fait qu’elle soit disponible en continu permet de refléter la normothermie du patient. Alors que certains patients vont être fébriles autour de 38,3°C, d’autres le seront dès 37,8°C. La moindre variation de température est enregistrée, même la nuit, pour pouvoir être analysée par le médecin dans son contexte.

Contexte médical
Comparaison des méthodes de mesure de température.

La précision et la sensibilité sont des critères essentiels pour établir un diagnostic.


Thermodiag en milieu hospitalier : preuve par l'usage
Retour d’un pilote réalisé en milieu hospitalier en service oncologie dans des conditions de soins réelles.
Objectifs : mesurer l’intégration de Thermodiag dans les pratiques infirmières, sa fiabilité en continu et sa capacité à détecter précocement les épisodes fébriles chez des patients à haut risque.
Résultats :
- Fièvre détectée jusqu’à 2h avant la méthode tympanique,
- Épisodes fébriles nocturnes détectés uniquement par Thermodiag,
- 1 seul geste d’équipement/24h vs 7,3 mesures manuelles/jour en moyenne,
- 100% de données exploitables hors erreurs de manipulation mineures,
- Autonomie totale du personnel infirmier après formation rapide,
- Réduction des erreurs de transcription observée jusqu’à 1,04 °C d’écart.
Qu’est-ce que le sepsis ?
Le sepsis est une réaction excessive du système immunitaire à une infection causant des lésions aux organes. Sans détection rapide et traitement adapté, il peut entraîner un choc septique, une défaillance multiple des organes, voire le décès.
La fièvre, premier signe d’alerte, doit être surveillée de près pour augmenter les chances de survie.
Quels sont les seuils de température de la fièvre chez l’adulte ?
Il est d’usage de parler de fièvre lorsque la température corporelle chez un sujet adulte s’élève à 38°C le matin et 38,3°C le soir. Mais plusieurs critères entrent bien souvent en jeu dans la mesure et le diagnostic qui en découle :
- Le type de dispositif utilisé et les recommandations cliniques qui peuvent varier en fonction des praticiens, établissements voire même services (ajout de 0,5°C ou +0,3°C)
- L’état de santé du patient : la température tympanique peut ne pas être fiable en présence d’un bouchon ou d’un obstacle dans le conduit auditif par exemple.
- L’âge du patient : chez les personnes âgées, la température corporelle est souvent plus basse. La fièvre peut donc être absente même en cas d’infection grave : une élévation modérée mais persistante peut alors être cliniquement significative.
Selon l’OMS, 40% des décès en soins intensifs sont dûs à un sepsis.

Innover pour détecter encore plus tôt
La médecine évolue vers une approche plus préventive, proactive et centrée sur le patient où l’analyse continue des données permet d’anticiper les déséquilibres physiologiques avant qu’ils ne deviennent cliniquement visibles.
Thermodiag s’inscrit pleinement dans cette dynamique : en enregistrant la température centrale 4 fois par minute et en modélisant le rythme circadien propre à chaque individu, il identifie les écarts subtils par rapport au profil thermique de référence. Cette capacité à individualiser le suivi ouvre la voie à une médecine personnalisée, réactive et prédictive, en particulier pour les patients à fort risque infectieux.

Estimation de la température centrale à partir de capteurs non invasifs
Pour estimer de manière fiable la température centrale à partir de données issues de capteurs de surface, F2D Medical a développé, en collaboration avec un partenaire en datascience , un algorithme d’estimation basé sur des techniques avancées de traitement de données et d’apprentissage statistique.
L’objectif : atteindre un niveau de précision compatible avec les attentes cliniques, tout en assurant une exécution optimisée sur des terminaux Android embarqués, à faible consommation énergétique.
Le développement s’est structuré autour de plusieurs étapes clés :
- Constitution d’une base de données multicapteurs : signaux de capteurs thermiques, optiques et inertiels, synchronisés sur des mesures de référence lors d’essais cliniques avec plus de 300 sujets représentatifs de la population adulte tant en âge qu’en sexe et diversité morphologique
- Développement de modèles prédictifs sur mesure : plusieurs algorithmes ont été testés et affinés selon des critères de robustesse, d’interprétabilité et de rapidité d’exécution.
- Mise en œuvre d’une architecture modulaire : l’application Thermodiag embarque plusieurs modèles complémentaires, capables de s’adapter dynamiquement à différentes situations cliniques (repos, mouvement, phase postopératoire, etc.) pour assurer un suivi continu, contextualisé et pertinent.
- Intégration embarquée sécurisée : les algorithmes sont encapsulés dans une application Android capable de fonctionner en local, sans dépendance réseau, avec une traçabilité complète des prédictions. Les données peuvent être archivées sur serveurs HDS et exportées vers les systèmes d’information hospitaliers via API sécurisée ou messagerie MSSanté.
Parallèlement, F2D Medical poursuit des travaux de R&D sur :
- l’enrichissement de cas cliniques par données augmentées,
- la spécialisation des modèles prédictifs par type de pathologie (oncologie, réanimation, gériatrie…),
- l’intégration de seuils intelligents selon le profil du patient permettant d’adapter les messages d’alerte.
Ce développement technologique incarne la volonté de F2D Medical de faire converger l’intelligence artificielle, la précision clinique et la réalité opérationnelle du terrain pour ouvrir une nouvelle ère dans le suivi prédictif des patients à haut risque infectieux.
Qu’est-ce que le sepsis ?
Le sepsis est une réaction excessive du système immunitaire à une infection causant des lésions aux organes. Sans détection rapide et traitement adapté, il peut entraîner un choc septique, une défaillance multiple des organes, voire le décès.
La fièvre, premier signe d’alerte, doit être surveillée de près pour augmenter les chances de survie.
Quels sont les seuils de température de la fièvre chez l’adulte ?
Il est d’usage de parler de fièvre lorsque la température corporelle chez un sujet adulte s’élève à 38°C le matin et 38,3°C le soir. Mais plusieurs critères entrent bien souvent en jeu dans la mesure et le diagnostic qui en découle :
- Le type de dispositif utilisé et les recommandations cliniques qui peuvent varier en fonction des praticiens, établissements voire même services (ajout de 0,5°C ou +0,3°C)
- L’état de santé du patient : la température tympanique peut ne pas être fiable en présence d’un bouchon ou d’un obstacle dans le conduit auditif par exemple.
- L’âge du patient : chez les personnes âgées, la température corporelle est souvent plus basse. La fièvre peut donc être absente même en cas d’infection grave : une élévation modérée mais persistante peut alors être cliniquement significative.
Selon l’OMS, 40% des décès en soins intensifs sont dûs à un sepsis.

Le Thermodiag sera un outil de sécurité essentiel. Cette détection précise est essentielle pour évaluer les infections sévères.Dr Coralie PrebetMédecin Oncologue
Être le moins invasif possible est un objectif constant, que ce soit pour le confort du patient, mais surtout pour limiter les risques iatrogènes et infectieux. La mesure non invasive de paramètres vitaux tels que la température avec une précision d’un dispositif invasif est un réel progrès et doit devenir un standard.Dr Joris GallandMédecin Interniste
Thermodiag ultra portable, léger et compact permet d’être transporté sans difficulté.Dr Thomas DumontierMédecin Urgentiste
Qu’est-ce que le sepsis ?
Le sepsis est une réaction excessive du système immunitaire à une infection causant des lésions aux organes. Sans détection rapide et traitement adapté, il peut entraîner un choc septique, une défaillance multiple des organes, voire le décès.
La fièvre, premier signe d’alerte, doit être surveillée de près pour augmenter les chances de survie.
Quels sont les seuils de température de la fièvre chez l’adulte ?
Il est d’usage de parler de fièvre lorsque la température corporelle chez un sujet adulte s’élève à 38°C le matin et 38,3°C le soir. Mais plusieurs critères entrent bien souvent en jeu dans la mesure et le diagnostic qui en découle :
- Le type de dispositif utilisé et les recommandations cliniques qui peuvent varier en fonction des praticiens, établissements voire même services (ajout de 0,5°C ou +0,3°C)
- L’état de santé du patient : la température tympanique peut ne pas être fiable en présence d’un bouchon ou d’un obstacle dans le conduit auditif par exemple.
- L’âge du patient : chez les personnes âgées, la température corporelle est souvent plus basse. La fièvre peut donc être absente même en cas d’infection grave : une élévation modérée mais persistante peut alors être cliniquement significative.
Selon l’OMS, 40% des décès en soins intensifs sont dûs à un sepsis.



